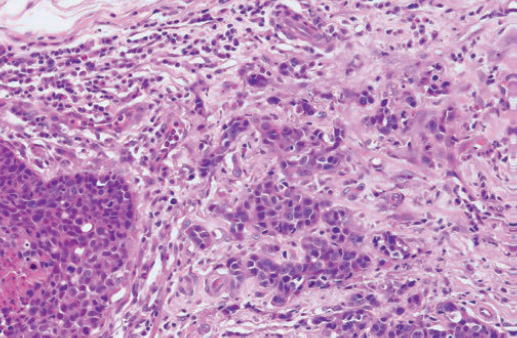

1/50
Looks like no tags are added yet.
Name | Mastery | Learn | Test | Matching | Spaced | Call with Kai |
|---|
No analytics yet
Send a link to your students to track their progress
Gonads
ovaries and testes (sex glands)
what are the 3 sequential series of events that occur during normal sexual development?
1. Establishment of sex chromosomes at fertilisation (XX or XY), including the sex determining region on Y (SRY).
2. Depending on the presence of SRY or not then determines how the modelling of embryonic gonadal tissue occurs (ovaries or testes form).
3. This gonadal tissue permits controlled, programmed regression and growth of different parts of the indifferent tubular and external genital tissues. This is referred to as the establishment of genital phenotype (genitals develop as female or male phenotype).
E.g.- AMH produced the Sertoli cells of the male gonads causes regression of the paramesonephric ducts, preventing female reproductive structures from forming (fallopian tubes, uterus, vagina). Also the presence of testosterone, produced by the Leydig cells in the male gonads makes the mesonephric ducts develop into the epididymis, vas deferens, seminal vesicles and ejaculatory ducts. Without testosterone the mesonephric duct regresses.

What is the SRY gene?
sex determining region of the Y chromosome that causes testicles to descend and male sex organs to form if the Y chromosome is present
Do females have the SRY gene?
No, females do not have the SRY (Sex-determining Region Y) gene because it is located on the Y chromosome, which females (XX) lack.
Karotype
The number and visual appearance of the chromosomes in the cell nuclei of an organism or species (a picture of all the chromosome in a cell arranged in pairs).

How are disorders of Sexual Development (DSD) classified?
Classification based on whether karyotype is abnormal or normal based on the assessment of:
1. Sex chromosomes (XX or XY) and presence or absence of genes (such as the sex determining region of the Y chromosome- SRY).
2. Gonadal type (whether or not ovaries or testes have developed in line with genetic sex determination)
3. Genital phenotype (whether or not male or female reproductive tract has developed in line with gonadal type and genetic sex determination)
What are myriad mammals?
Female mammalians with XX sex chromosomes and abnormal sexual development are myriad (so they have XX chromosomes so are SRY negative but have ovarian DSD due to mutations or abnormalities in ovarian development or hormone regulation).

How does XX SRY negative ovarian DSD manifest?
Some gene mutations of genes essential for ovarian development and function can result in DSD like:
- Ovotesticular DSD (both ovarian and testicular tissue present).
- Excess androgens meaning XX females develop characters associated with male hormones (virilisation) like ambiguous genitalia at birth.
BUT MOSTLY- The majority are normal females with a minor anomaly, such as cystic remnants of ducts or tubules.

What is chimerism?
Organism whose cells are derived from 2 or more zygotes

What is the most common type of chimerism?
bovine freemartinism

What is bovine freemartinism?
The bovine freemartin is a well-known example of intersex development in cattle that happens when a female calf (XX) is born as a twin alongside a male calf (XY) and is born with non-functioning ovaries (sterile). This condition is a result of shared blood circulation between the two foetuses during pregnancy.

more indepth about why freemartins occur
- In about 90% of cattle twin pregnancies, the placenta of the twins forms vascular connections (called placental anastomoses) between the two foetuses. This connection allows blood to be exchanged between both twins, allowing for the exchange of haematopoietic cells (so she has XX and XY WBC populations). This is called blood cell chimerism. There can also be chimerism due to receiving XY stem cells, with XY vells found in skin, gonads, and even internal organs. Also, Since the blood vessels of the twins are fused, some freemartins have XY endothelial (blood vessel lining) cells in their tissues.
- This placental anastomoses also means the female foetus receives male hormones (testosterone and Anti-Müllerian Hormone, AMH) from the male twin.
- These testis-determining factors from the male foetus travel through the shared bloodstream to the female and causes regression of the female's paramesonephric ducts, (which would normally develop into the uterus, fallopian tubes, and upper vagina).
- The female's reproductive organs becoming underdeveloped/abnormal which means they are born sterile.
- Rarely, some freemartins develop ovotesticular DSD (mixed gonads but still non-functional so still sterile), making them true hermaphrodites because they have received male XY stem cells that affected their gonadal development.
What is a true hermaphrodite?
A true hermaphrodite has both ovarian tissue and testicular tissue.
These tissues can be separate (one ovary, one testis) or combined into an ovotestis (a single gonad containing both ovarian and testicular structures).
This leads to ambiguity of external or internal genitalia or both- and the vast majority are infertile.

What is the karyotype of a true hermaphrodite?
True hermaphrodites can have different karyotypes:
- XY (less common)
- XX/XY (chimera- rare)
- XX (most common)


What is this?
Dog: ovotestis
What is a pseudohermaphrodite?
Has gonads of one sex but ambiguous or opposite-appearing genitalia
True Hermaphrodite = Has both ovarian and testicular tissue.
What is a male pseudohermaphrodite?
The karyotype is XY.
Gonads are recognisable as testis.
Incompletely masculinised and ambiguous external and internal genitalia.
What is a female pseudohermaphrodite?
The karyotype is XX.
Gonads are recognisable as ovaries.
Feminine (ambiguous in a few cases) internal genitalia, masculinised external genitalia.
List different ovarian pathologies
- Ovotestis
- Ovarian cysts
- Paraovarian cysts
- Neoplasms
What types of ovarian cysts can you get? (3)
- Follicular cysts and luteinised cysts
- Cystic rete ovarii
- Cysts of the subsurface epithelial structures (SES)
What paraovarian cysts can you get? (3)
- Cystic epophoron or paraoophoron (cysts of mesonephric tubules)
- hydatids or Morgani (cysts of paramesonephric ducts)
- cyst of mesonephric duct
Sex cord
Tissue that supports the ovaries/testicle reproductive cells
List the different neoplasms that can affect the ovary
- Sex cord-stromal tumours
- Tumours of the surface epithelium and the SES
- Germ cell tumours
- Other rarer tumours
What stress cord-stromal tumours can you get affecting the ovaries? (2)
Granulosa cell tumours (thecoma or luteoma) that have a propensity to be hormonally active
What tumours or the surface epithelium and the SES can you get affecting the ovaries?
- Papillary adenoma
- Cystic adenoma
- Papillary adenocarcinomas
- Cystic adenocarcinomas
What germ cell tumours can you get affecting the ovaries? (2)
- Teratoma (generally benign)
- Dysgerminoma (rare)
What other rare neoplasms can you get affecting the ovaries?
Endodermal sinus tumours (yolk sac tumours),
choriocarcinomas,
embryonal carcinomas
What type of tumour is granulosa cell tumour?
- Most common sex cord-stromal tumour
- Usually non-malignant tumours in any species

What is the gross structure of a granulosa cell tumour?
Large tumours that include both solid and cystic areas that are either:
- Multinodular or symmetrical
- Unilateral or bilateral
- Include both solid and cystic areas
- With or without scattered areas of haemorrhagic necrosis

What is the histopathology of granulosa cell tumours?
A variety of patterns may occur in different areas: solid sheets, islands, cords, trabeculae, nests. Sometimes presence of Call Exner bodies.

Call-exner bodies description and microscopic appearance
Call-Exner bodies are small, fluid-filled spaces that form within the granulosa cells of the ovarian tumor.
They consist of follicular cells arranged in a rosette-like or circular pattern, and inside these spaces, there is typically eosinophilic fluid. The spaces resemble follicles but are not fully developed.

List the pathologies of the uterus and external genitalia
- Congenital lesions of the uterus
- Inflammatory disorders of the uterus
- Neoplasms of the uterus
- Neoplasms of the external genitalia
What are the main congenital lesions of the uterus? (2)
- Segmental aplasia
- Mesonephric cysts
Endometritis vs metritis
Inflammation limited in extent to the endometrium is termed endometritis; involvement of the entire thickness of the wall is metritis (endo+myometrium).
What causes inflammatory disorders of the uterus?
Result of ascending infection when the cervix is open, at oestrus (uterine resistance varies during the oestrus cycle with susceptibility greatest during the luteal phase), parturition, or during post-partum period.
what does uterine resistance vary upon
Uterine resistance varies during the oestrous cycle, susceptibility being greatest during the luteal phase of the cycle.
What infections can inflame the uterus?
- Haematogenous infections: Less common and are usually involved in some microbial/viral disorders, and they usually occur during pregnancy and can cause abortion.
- Pyometra: Acute or chronic suppurative (forming discharge/pus) infection of the uterus with accumulation of pus in the uterine lumen.

What are the main neoplasms of the uterus? (2)
- Smooth muscle tumours (leiomyoma)
- Endometrial carcinoma in the cow
What are the main neoplasms of the external genitalia? (4)
- Smooth muscle tumours (leiomyoma)
- Canine transmissible venereal tumour
- Squamous cell carcinoma
- Fibropapilloma of the vulva in cattle
what phase of the oestrus cycle has high progesterone
luteal
What bacteria mainly cause mastitis in cows?
Bovine mastitis typically due to ascending infection of the gland with bacteria as the most common pathogens:
-Streptococcus agalactiae and some types of Staphylococcus aureus are obligate parasites of the gland and inevitable pathogens.
- But the great majority of infections are opportunistic (E. coli, Enterobacter, Klebsiella, Citrobacter, Serratia).
- Other pathogens are: Mycoplasma bovis, Nocardia spp., Mycobacterium bovis, fungi and algae (Prototheca zopfii).


Describe the histopathology of a mammary gland in a cow with bovine mastitis
Neutrophils are within glandular acini in suppurative (pus forming) mastitis in a cow.
in the ewe and goat what pathogens are likely to cause mastitis
S. aureus, Mannheimia haemolytica,
Corynebacterium pseudotuberculosis,
T pyogenes,
Mycoplasma agalactiae.
The Maedi Visna virus can cause mononuclear interstitial mastitis in the ewe.

Describe this image
Bovine: coliform (bacterial infection of coliform bacteria) mastitis glandular necrosis and marked subcutaneous oedema
Coliform bacteria
Bacteria that live in the intestines (including the colon), defined as rod-shaped gram-negative non-endospore forming bacteria that ferment lactose with the production of acid and gas at 35–37°C.
E.g. E.coli
Name the two kinds of mammary tumours found in small animals
- Benign mammary tumours
- Mammary carcinomas
Benign mammary tumours in dogs
more than half of mammary masses, often have epithelial (adenoma) and mixed myoepithelial/mesenchymal component (complex mammary adenoma with epithelial and myoepithelial components).


Describe the histological appearance of benign mammary tumours in small animals
Histologically benign appearance, including lack of invasion, minimal anisokaryosis/pleomorphism, low mitotic index.
Mammary carcinomas in dogs
Large number of subtypes, wide heterogeneity taken into account by the grading of different factors:
Differentiation, tubule formation, nuclear pleomorphism, mitoses per 10 HPF. The anaplasia, the high nuclear grade and mitotic rate are negative prognostic factors, as well as the stromal invasion and the presence of neoplastic emboli.

Mammary carcinomas in cats
About 75-90% are intermediate or high grade carcinomas, simple and much less heterogeneous (types: tubulopapillary, solid, or cribriform carcinomas).
describe this histological image of a simple canine mammary carcinoma
infiltrating the stroma
not forming tubules
disordered